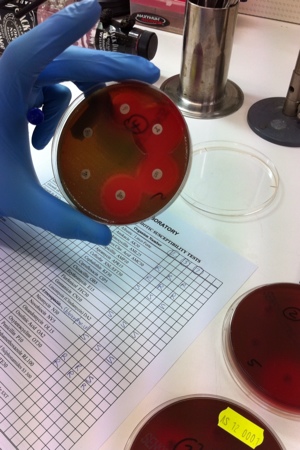

Those antibiotics commonly available at fish shops include tetracycline and triple sulfa. Illegally, nitro furans and kanamycin are sometimes purchased/imported.
Before we dive right into the answer on which is the best antibiotic to use to treat such fish, have a look at this picture.
In this diagram is a table of the antibiotic sensitivities of a said fish/aquatic bacteria. ‘S’ stands for sensitive and in theory, it should be effective. ‘R’ stands for resistant and in theory, will have negligible effect on the pathogen.
Whenever I choose to test fish with antibiotics, it’s a good idea to run cultures and an antibiotic sensitivity panel to determine:
1. What bacteria you have?
2. Is it a primary pathogen or secondary invader?
3. Which antibiotic would have the greatest effect if necessary?
In this picture, you may notice that not all antibiotics will work every time. It’ll depend on the bacteria and on the strain. It may also depend on what you’ve used in the past. Consider evidenced based medicine, rather than a ‘quick fix’ recommended by a friend.
In another picture, the antibiotic sensitivity panel is not looking as bad. The discs are antibiotic impregnated cards and the space seen around them (areas of inhibited bacterial growth) is measured and compared with the standards to check if they are effective.

Hi Richmond, that chart you have about the “bacteriology laboratory”, would you be able to email to me at fampet@tpg.com.au please. I am not a science person and trying to undertand bacteria in the aquarium. Your chart would be a great help. Thanks
LikeLike
Hi Darren,
That’s just a list of antibiotics and the bacteriologist will write next to each one that’s been tested with the impregnated disc, whether it is resistant or sensitive. Based on these findings, it may alter the antibiotics you use.
Different bacterial isolates, even if it’s the same species, may have a different antibiotic sensitivity pattern. So the chart is only useful for the one case.
Richmond
LikeLike
Oh ok. Thanks Richmond. cheers
LikeLike